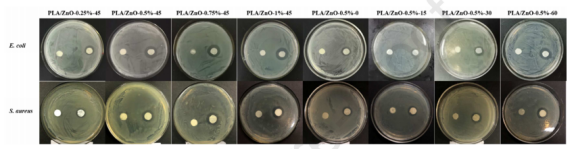

DOI:10.1016/j.lwt.2020.110072
在这项研究中,通过静电纺丝技术开发了由聚乳酸(PLA)和超声分散的ZnO纳米颗粒(NPs)构成的生物聚合物基抗菌纤维膜。全面研究了不同ZnO NPs含量的膜的形貌、力学性能、热力学特性和抗菌性能。结果表明,当ZnO含量为0.5wt%(PLA/ZnO-0.5%)时,可获得最佳性能。具体而言,复合膜的抗张强度和断裂伸长率分别为6.85±0.19MPa和74.90±0.59%,对大肠杆菌和金黄色葡萄球菌的抑制带分别为15.02±0.18mm和14.74±0.06mm。此外,45分钟的超声处理时间可改善复合膜的热、紫外线(UV)阻隔和抗菌性能。超声作用45分钟时,PLA/ZnO-0.5%对大肠杆菌和金黄色葡萄球菌的抑制带分别为18.11±0.15mm和15.80±0.11mm。因此,PLA/ZnO-0.5%可用于食品包装,以提供抗菌作用和紫外线阻隔。

图1.不同纳米纤维膜的典型SEM图像(a)5000x和(b)50000x(超声时间为45分钟),以及(c)不同复合纳米纤维膜的纳米纤维直径分布直方图。

图2.(a-d)PLA/ZnO-0.5%纳米纤维膜的EDS图像,(e)EDS光谱和元素。

图3.(a)ZnO NPs,(b)PLA,(c)PLA/ZnO-0.25%,(d)PLA/ZnO-0.5%,(e)PLA/ZnO-0.75%,(f)PLA/ZnO-1%(未经超声处理),以及不同超声时间下(g)PLA/ZnO-1%-15,(h)PLA/ZnO-1%-30,(i)PLA/ZnO-1%-45和(j)PLA/ZnO-1%-60纳米纤维膜的FTIR光谱。

图4.PLA膜和不同PLA/ZnO膜在不同超声时间下的(a)抗张强度和(b)断裂伸长率。*表示显著差异(p<0.05)。

图5.PLA膜和不同PLA/ZnO纳米纤维膜在不同超声时间下的(a)溶解度和(b)溶胀度。*表示显著差异(p<0.05)。

图6.在超声作用下45分钟,PLA和不同PLA/ZnO纳米纤维膜的照片。
图7.PLA和不同PLA/ZnO纳米纤维膜对(a)大肠杆菌和(b)金黄色葡萄球菌在37℃孵育24h后生长抑制的影响。